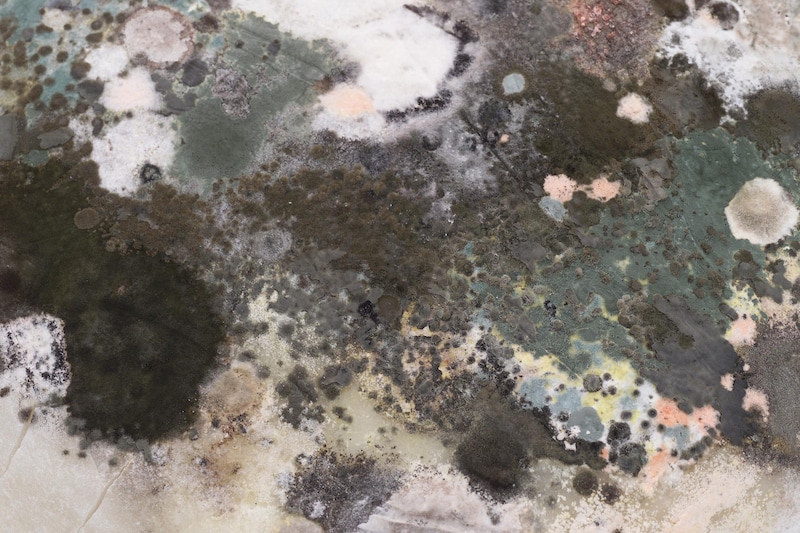

引っ越し後などに「咳が続く」「咳がひどい」は何の病気?
咳が続くのはツライものです
以下に、咳の主な原因をまとめてみました。ご自身の症状と照らし合わせて読んでみてください。
<目次>
特に晴れた日に咳が出る場合の原因……花粉・黄砂・大気汚染
■花粉晴れた日や、遠くに霞がかかっているように見える日に咳が出る場合、原因は引っ越しではなく、花粉や黄砂、大気汚染によるものの可能性が考えられます。
4月ならスギ花粉、5月ならヒノキ花粉です。スギ花粉症の方は、ヒノキ花粉にも反応することが多いので、スギのシーズンが終わっても、咳、鼻水、くしゃみ、鼻づまりが続く場合は、花粉症対策をやめないようにしましょう。
花粉による咳の対策方法としては、花粉を減らす方法と、体につく花粉を減らす方法を実践しましょう。詳しくは「花粉飛散カレンダー…夏・秋の花粉症状も」「軽症から最重症まで…重症度で変わる花粉症の治療法」「花粉症の治療」「体質改善?免疫療法って何?」「 副鼻腔炎の原因・症状・診断・治療」「洗濯物に花粉をつけない方法」「花粉も黄砂もまとめて解決! 空気清浄機」などをご覧ください。
■黄砂
花粉アレルギーはなさそうなのに咳がひどい場合、環境省黄砂飛来情報で、黄砂の飛散量をチェックしてみましょう。黄砂が多いと言われるタイミングで咳がひどくなる場合、黄砂が原因かもしれません。
3月から5月までに飛来する黄砂には、様々な物質、有害物質も含まれていますので、注意が必要です。
対策方法としては、花粉より小さいウイルスをブロックできるマスクを使用しましょう。詳しくは「黄砂が飛ぶと、アレルギーが悪化!?」「有害物質を運ぶ黄砂、その成分について」「黄砂アレルギー対策で、咳・鼻水・湿疹予防」「花粉も黄砂もまとめて解決! 空気清浄機」などをご覧ください。
■大気汚染 もう一つ考えられるのは大気汚染です。咳のひどい時に、そらまめ君(環境省大気汚染物質広域監視システム)で大気の状態をチェックしましょう。光化学スモッグ発生している時に、咳をしていると、大気汚染が原因かもしれません。
対策方法としては、外出をなるべく避けること。詳しくは「黄砂アレルギー対策で、咳・鼻水・湿疹予防」をご覧ください。
引っ越し後、部屋にいると咳がひどくなる場合……カビ
![]() |
| カビはいたるところで生えます |
対策法としては、まずは湿度を下げることが重要です。「梅雨に向けてのカビ対策」「梅雨でもアトピーを吹き飛ばそう!」などもあわせてご覧ください。
また、カビが原因の肺炎になることもあります。「夏型過敏性肺臓炎」という病気があります。Trichosporon cutaneumというカビが原因で、アレルギー反応によって肺炎を起こします。「夏型」ですから、4月~8月ぐらいに多いです。この病気も家のカビが原因ですから、入院すれば治りますが、家の環境を変えないと退院してもまた肺炎になってしまいます。
室内が埃っぽく、掃除をしても咳が出る場合……ダニ・ホコリ
![]() |
| ダニはアレルギーに大敵です! |
引越しで、荷物についたホコリが飛んだだけでも、咳き込みは起こります。そのため、マスクをして、荷物を動かすことが大切になります。ダニは湿度が高くて、高温が大好きですから、湿度を落とすこと、花粉や黄砂と違って、換気が大切です。
まずは換気、掃除をしましょう。詳しくは「梅雨に向けてのダニ対策」「梅雨でもアトピーを吹き飛ばそう!」「天敵のダニ一掃! 頼れる掃除機の選び方」などをご覧ください。
新しい集団生活後に咳が止まらなくなった場合……百日咳・風邪など
■百日咳新学期で入学してからや、新しい会社に入社してから突然しつこい咳が止まらなくなった場合や、周りの人も同じような咳をしている場合、百日咳菌(Bordetella pertussis)という細菌が原因の場合も考えられます。百日咳を予防するために、DPT(ジフテリア・百日咳・破傷風)という三種混合ワクチンをしているわけですが、時間が経つと、抗体が低くなり、百日咳にかかってしまいます。百日咳が疑われたら、血液検査で確定診断が可能です。
疑わしい症状がある場合は、百日咳かどうか医療機関を受診して検査をうけましょう。詳しくは「 咳が長引く百日咳で、喘息・アトピー症状が悪化する?」をご覧ください。
■風邪
また、季節の変わり目でもある春は、咳、鼻を中心にしたライノウイルスによる風邪が流行する季節でもあります。ただの風邪の場合は2週間ほどで咳、鼻の症状は落ち着くことがほとんどです。もし風邪にしては長い場合は、医療機関を受診しましょう。一般的な風邪の原因にもなるコロナウイルスは冬がピークですが、春にかけて流行します。
また、コロナウイルスの中には「MERS(中東呼吸器症候群)」や「SARS(重症急性呼吸器症候群)」などの重症肺炎を起こすものもありますが、2019年年末に発生したSARS-CoV-2は、新型コロナウイルス感染症(COVID-19)を引き起こします。一部で重症肺炎を起こすこのウイルスは、2020年3月現在、世界的な流行になっています。換気が悪く、人が集まる場所や、人と人との距離が近い状況で感染が拡大するため、人が集まる行事が多い春も注意が必要です。詳しくは「新型コロナウイルス感染症の症状・知っておくべき注意点」をご参照ください
■マイコプラズマ
発熱があって、咳がひどい場合、マイコプラズマ肺炎の場合もあります。これも冬から春にかけて流行しやすい病気で、肺炎マイコプラズマ(Mycoplasma pneumoniae)という細菌によって起こります。飛沫感染しますので、集団生活をすることで感染が拡大します。人が集まる環境では感染する可能性があります。「マイコプラズマ肺炎の症状・治療法…原因・潜伏期間・感染経路も」をご参照ください。
■インフルエンザ
春になるとやや流行は落ち付いてきますが、インフルエンザBの流行は春先もまだ残る可能性があります。突然の高熱で、咳がひどい場合は、インフルエンザを疑ってもよいかもしれません。
■ヒトメタニューモウイルス
子どもの呼吸器の感染症の約5~10%、大人の呼吸器の感染症の約2~4%はヒトメタニューモウイルスによるものであると言われています。感染しやすい年齢は1~2歳ですが、一度感染しても十分な免疫を得ることができないため、何度も感染してしまいます。感染経路は主に飛沫感染で、人の咳、つばなどから感染します。また、ウイルスの付着した物を触って鼻などを触ると感染する接触感染もあります。流行時期は3~6月で、春に多いです。感染してから発症までの潜伏期間は約4~6日です。発熱、咳、鼻水など風邪のような症状が多いですが、乳幼児や高齢者では肺炎になることもあります。詳しくは「ヒトメタニューモウイルス」による感染症が増加中!」をご参照ください。
新築の家への引越し後に咳が続く場合……シックハウス症候群
建築物には、化学物質が使われています。新築の住宅や改装工事後、住宅建材や防腐剤から発生する揮発性化学物質などが原因で、住宅(ハウス)によって体調不良や健康被害(シック(病気))を引き起こす病気です。ホルムアルデヒド、トルエン、キシレン、ベンゼン、家の接着剤・木材の防腐剤・防虫剤・防蟻剤などが原因になります。対策としては、まずは換気をすることです。詳しくは「家が原因?「シックハウス症候群」」をご覧ください。
咳がいつでもどこでも止まらない場合……咳喘息・アトピー咳嗽
■咳喘息咳喘息は、喘鳴がなく、慢性に咳だけが続く病気です。詳しくは「 ゼーゼーしない咳症状が3週間以上続く「咳喘息」とは」をご覧ください。
■アトピー咳嗽
アトピー素因のある人が、痰のからまない咳を1ヶ月以上していたら、それはアトピー咳嗽かもしれません。「咳反射」の感度が亢進しすぎて、ちょっとしたことで咳をしてしまうのが、この病気です。詳しくは「アトピー咳嗽の原因・症状・治療法…1ヶ月以上続く咳」をご覧ください。
咳の原因をあきらかにするのは簡単ではありません。季節や天候、家に原因がある場合だけでなく、病気がひそんでいることもあります。咳が長引く場合は医療機関を受診し、適切に対処していくようにしましょう。
【関連記事】